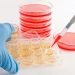

Cách thở này không những cung cấp đủ dưỡng khí mà còn giúp điều hòa các rối loạn tạng phủ. Điển hình là phương pháp tập thở của Bác sĩ Nguyễn Khắc Viện.
Phương pháp hít thở của Bác sĩ Nguyễn Khắc Viện
Bác sĩ Nguyễn Khắc Viện (1913-1997), học Đại học Y khoa Hà Nội rồi sang Pháp học, tốt nghiệp bác sĩ Nhi khoa năm 1941. Năm 1942, ông bị lao phổi nặng, điều trị ở Bệnh viện Saint Hilaire Du Touvet, Grenoble, Pháp.
Thời đó, bệnh lao chưa có thuốc chữa như bây giờ. Từ năm 1943-1948, ông phải chịu bảy lần phẫu thuật, cắt bỏ tám cái xương sườn, cắt bỏ toàn bộ lá phổi bên phải và một phần ba lá phổi bên trái.
Các bác sĩ Pháp nói ông chỉ có thể sống chừng hai năm nữa thôi. Nhưng ông đã tìm ra phương pháp thở để chữa bệnh cho mình, kết quả là ông đã sống đến 85 tuổi, nghĩa là sống thêm được 50 năm nữa, hoạt động tích cực, năng nổ trong nhiều lĩnh vực: bác sĩ, nhà văn, nhà báo, nhà hoạt động xã hội rất nhiệt tâm. Ông “tiết lộ” nhờ tập thở mà ông không bị stress, không bị mệt.
Phương pháp thở của Bác sĩ Nguyễn Khắc Viện không phải hoàn toàn mới mà chỉ là một sự tổng hợp của khí công, thiền, yoga, dưỡng sinh… được nhìn bằng sinh lý học hô hấp hiện đại của một người thầy thuốc.

Tư thế ngồi kiết già
12 câu dạy thở của ông như sau:
- Thót bụng thở ra
- Phình bụng thở vào
- Hai vai bất động
- Chân tay thả lỏng
- Êm chậm sâu đều
- Tập trung theo dõi
- Luồng ra luồng vào
- Bình thường qua mũi
- Khi gấp qua mồm
- Đứng ngồi hay nằm
- Ở đâu cũng được
- Lúc nào cũng được!

Thở khi đi bộ
Phương pháp này kết hợp giữa tập thở với đi bộ, thích hợp cho người cao tuổi, vừa đơn giản vừa phù hợp với điều kiện sinh hoạt. Đi nhanh hay chậm, ngắn hay dài tùy khả năng sức khỏe mỗi người.
Trong khi đi, kết hợp với thở bụng êm dịu và sâu theo công thức: 4 bước hít vào, nhớ phình bụng ra, 2 bước ngừng thở, rồi tiếp theo 8 bước thở ra, thót bụng lại. Việc tập luyện sẽ phát huy tác dụng tốt hơn khi đi bộ ở nơi thoáng khí, trong lành, tinh thần thư thái, thoải mái.

Thở bốn thì bằng nhau: Hít vào phình bụng, thở ra hóp bụng
- Thì 1: Hít vào từ từ và nhẹ nhàng bằng mũi, hít sâu, êm dịu kéo dài đến mức có thể chịu được, đồng thời phình bụng ra.
- Thì 2: Nín thở giữ hơi, thời gian bằng khi hít vào.
- Thì 3: Thở ra từ từ, êm nhẹ và kéo dài, đồng thời bụng thót vào hết cỡ, thời gian bằng thì 1.
- Thì 4: Nín thở, thời gian bằng thì 1. Lúc mới tập, người tập có thể đếm 1, 2, 3, 4, 5 ở mỗi thì. Sau tăng thời gian lên bằng cách đếm đến 7, 8, 9, 10.
Cái khó của phương pháp này là phải hít vào đến mức tối đa, lại nín thở kéo dài, sau đó mới thở ra từ từ, ít người tập có đủ sức nín thở lâu như thế mà cơ bắp vẫn thả lỏng, nét mặt bình thản thoải mái. Bạn cần tập từ từ, nâng dần thời gian mỗi thì thở lên đến mức tối đa.

Thở theo Yoga
Người tập có thể tập thở trong tư thế nằm, đứng, ngồi trên ghế, nhưng tốt nhất là ngồi tư thế hoa sen (lòng bàn chân phải ngửa lên đùi trái và ngược lại) hay còn gọi là tư thế kiết già; tư thế kiểu nửa hoa sen (lòng bàn chân phải ngửa trên bụng chân trái), hay còn gọi là tư thế bán già.
Phương pháp thở Yoga là nhẹ nhàng, chậm rãi, đều đặn theo ba thì: hít vào, giữ hơi, thở ra; hoặc bốn thì: hít vào, giữ hơi, thở ra, nín thở. Tâm trí chỉ hoàn toàn chú trọng vào hoạt động hô hấp và lộ trình của hơi thở. Nếu thở bốn thì, nhịp độ phân bổ lý tưởng là 1-4-2-4, nghĩa là thời gian hít vào 1, thời gian giữ hơi 4, thời gian thở ra 2 và thời gian nín thở 4.
Khi mới bắt đầu tập sẽ rất khó thực hiện, sau một thời gian, bạn mới thở được như thế. Phương châm của Yoga là thoải mái, phù hợp với mỗi cá nhân, tránh khiên cưỡng, nóng vội.
Vì vậy, bước đầu tập thở bốn thì hoặc ba thì, mỗi người hãy tự tìm cho mình một nhịp độ thích hợp với sức khỏe của mình. Không cố gắng quá sức, đồng thời cũng không quá dễ dãi tùy tiện. Bạn có thể tập theo nhịp độ 1-2-2-2… rồi nâng dần cho tới nhịp độ lý tưởng.
Lưu ý khi hít vào và thở ra đều qua mũi nhưng không để cho cánh mũi phập phồng. Thở bằng bụng: hít vào thì phình bụng, thở ra thì thót bụng và co hậu môn lên, thở thật nhẹ nhàng và chậm rãi.
Nên chú ý dẫn dắt hơi thở theo một lộ trình, chẳng hạn bạn có thể tưởng tượng hơi thở vào qua mũi, ngược lên đỉnh đầu, ra sau gáy, dọc theo xương sống… Tâm trí chỉ hoàn toàn chú trọng vào hoạt động hô hấp và lộ trình của hơi thở.